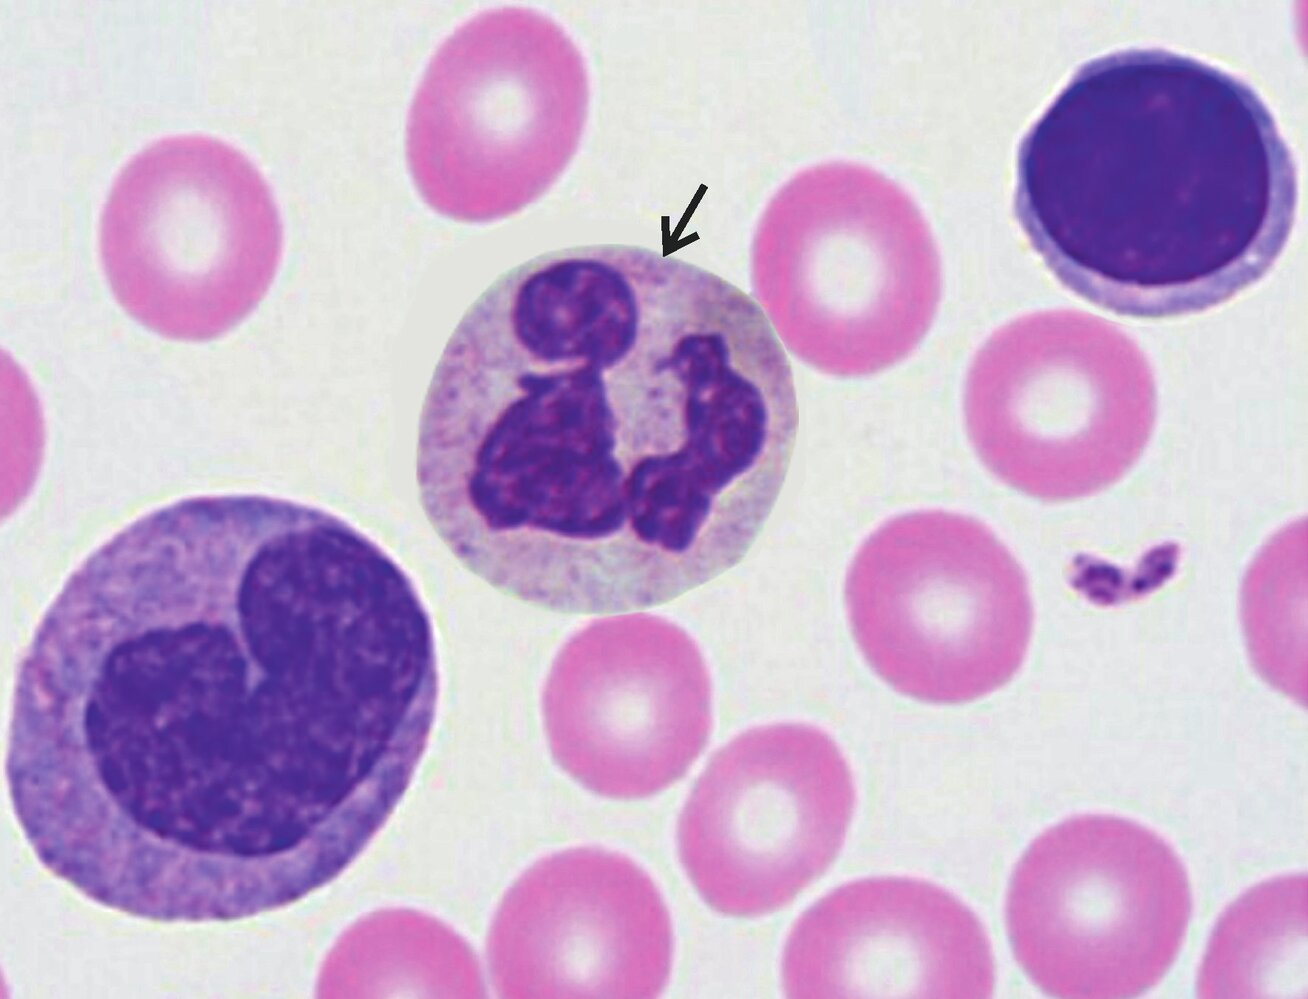
<p>13. In the blood smear shown in the image, a cell is marked with an arrow.</p><p>Under normal (physiological) conditions, how many cells of this type are typically found in one microliter (μL or mm³) of blood in an adult human?</p><p>A. 3 to 5</p><p>B. 100 to 500</p><p>C. 2,000 to 5,000</p><p>D. 200,000 to 300,000</p><p>E. 4 million to 5 million</p>
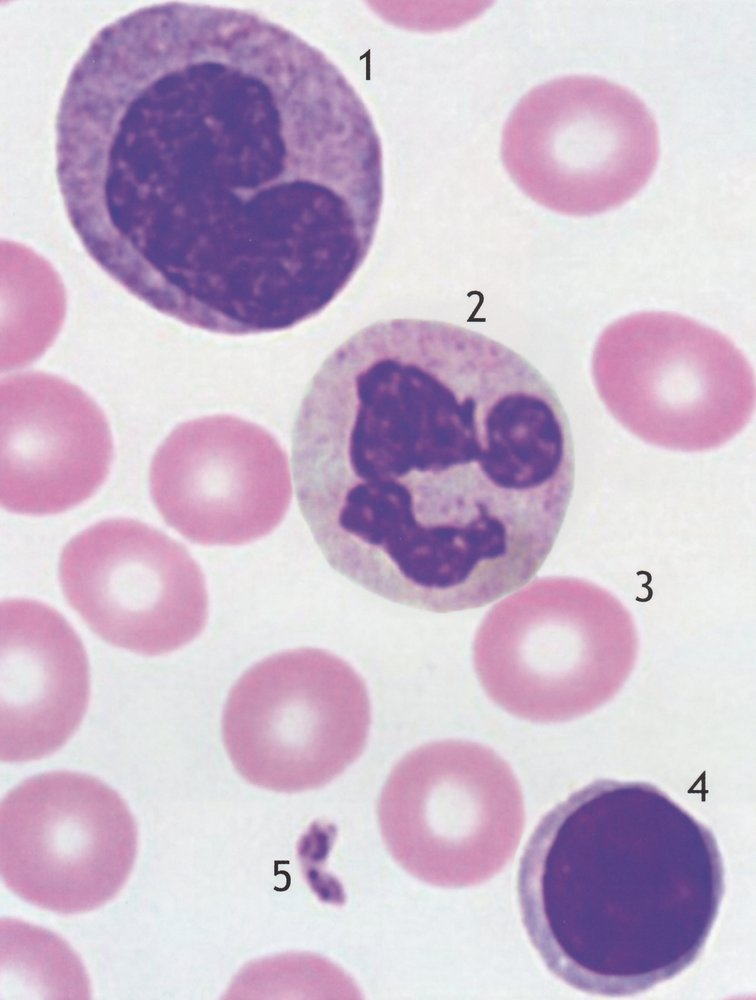
<p>C. 2,000 to 5,000</p>

1/75
Geschlechtsorgane und Sexualität
Name | Mastery | Learn | Test | Matching | Spaced | Call with Kai |
|---|
No analytics yet
Send a link to your students to track their progress
1. In patients with paroxysmal nocturnal hemoglobinuria (PNH), red blood cells (erythrocytes) are at risk of being spontaneously destroyed by the complement system. This happens because these red blood cells have reduced levels of CD59 on their surface. In healthy individuals, CD59 blocks the formation of the membrane attack complex (MAC), which is the structure that destroys cells. One possible treatment option involves monoclonal antibodies that neutralize a specific complement component.
Which of the following complement components should most likely be neutralized to prevent the spontaneous formation of the membrane attack complex (MAC)?
A. C1r
B. C1s
C. C2
D. C4
E. C5
E. C5

2. Implantation, also called nidation, is the process where the early embryo (blastocyst) attaches to the lining of the uterus (endometrium).
Approximately how many hours or days after fertilization of the egg does implantation of the blastocyst into the uterine lining typically begin?
A. 12 hours
B. 24 hours
C. 2 days
D. 6 days
E. 12 days
D. 6 days

3. The structure of the fetal membranes can vary in twins.
Which of the following placental arrangements and membrane conditions occur in identical (monozygotic) twins, but typically not in fraternal (dizygotic) twins?
A. Shared amniotic sac (amnion), shared placenta
B. Shared amniotic sac, separate placentas
C. Shared chorionic sac (chorion), separate placentas
D. Separate chorionic sacs, shared placenta
E. Separate chorionic sacs, separate placentas
A. Shared amniotic sac (amnion), shared placenta

4. Heart valve defects can be caused by developmental problems during the separation of the atrioventricular canal.
Which process leads to the final formation of the openings (ostia) for the mitral and tricuspid valves?
A. Fusion of the conus arteriosus, truncus arteriosus, and aorticopulmonary septum
B. Fusion of the endocardial cushions
C. Closure of the interventricular foramen
D. Closure of the foramen primum
E. Closure of the foramen secundum
B. Fusion of the endocardial cushions

5. The branchial arches (pharyngeal arches) play a crucial role in the development of the head and neck structures.
Which definitive structure develops from the 1st pharyngeal arch?
A. Thyroid cartilage (Cartilago thyroidea)
B. Greater horn of the hyoid bone (Cornu majus ossis hyoidei)
C. Stylohyoid ligament (Ligamentum stylohyoideum)
D. Incus (anvil bone in the middle ear)
E. Stapes (stirrup bone in the middle ear)
D. Incus (anvil bone in the middle ear)

6. Cells and tissues can adapt or respond to their surroundings in different ways.
Which of the following descriptions best defines the term “hyperplasia”?
A. Cell death caused by external damage to existing cells of one cell type in a tissue
B. Programmed cell death (apoptosis) of existing cells of one cell type in a tissue
C. Conversion of cells from one type to another within a tissue (metaplasia)
D. Enlargement of existing cells of one cell type in a tissue (hypertrophy)
E. Increase in the number of existing cells of one cell type in a tissue
E. Increase in the number of existing cells of one cell type in a tissue

7. Glial cells are essential for the proper functioning of neurons.
Which type of glial cell belongs to the mononuclear phagocyte system (MPS)?
A. Astrocytes
B. Ependymal cells
C. Microglial cells
D. Oligodendrocytes
E. Satellite cells
C. Microglial cells

8. In exocrine glands, we differentiate between holocrine, merocrine, and apocrine types of secretion.
Which gland(s) typically use holocrine secretion?
A. Parotid gland (Glandula parotidea)
B. Lactating mammary gland
C. Large sweat glands (apocrine glands)
D. Small sweat glands (eccrine glands)
E. Sebaceous glands (Talgdrüsen)
E. Sebaceous glands (Talgdrüsen)
9. Immunoglobulins (antibodies) can be found dissolved in blood plasma, attached to cell membranes, or present in certain body secretions.
Which class of immunoglobulin is generally the most common antibody found in body secretions?
A. IgA
B. IgD
C. IgE
D. IgG
E. IgM
A. IgA
10. Reticular fibers are net-like fibers found not only in reticular connective tissue, but also as part of the basement membrane and as a supportive network around epithelial layers, glandular units, and capillaries.
Which type of collagen mainly makes up these fibers?
A. Type II collagen
B. Type III collagen
C. Type IV collagen
D. Type V collagen
E. Type VI collagen
B. Type III collagen


11. The structures marked with X in the image:
A. Are involved in the sense of smell (olfaction)
B. Contain microvilli
C. Are typical of the squamous epithelium of the vagina
D. Are surrounded by respiratory epithelium
E. Are innervated by spinal nerves
B. Contain microvilli


12. The image shows a tissue section.
Which molecule in this tissue has elastic properties and stretches from the Z-line (Z-disc) to the M-band (M-line)?
A. Actin
B. Myosin
C. Titin
D. Elastin
E. Aggrecan
C. Titin
13. In the blood smear shown in the image, a cell is marked with an arrow.
Under normal (physiological) conditions, how many cells of this type are typically found in one microliter (μL or mm³) of blood in an adult human?
A. 3 to 5
B. 100 to 500
C. 2,000 to 5,000
D. 200,000 to 300,000
E. 4 million to 5 million
C. 2,000 to 5,000

14. Tissue samples from different organ systems can be identified under the microscope or in images by specific features.
The image shows, among other structures:
A. Cortex and medulla of the adrenal gland
B. Ciliated epithelium of the fallopian tube (Tuba uterina)
C. Germinal epithelium of the testis
D. Non-keratinized stratified squamous epithelium of the vagina
E. Transitional epithelium of the urinary bladder
C. Germinal epithelium of the testis


15. Which organ or tissue is shown in the image?
A. Thymus
B. Spleen (Milz)
C. A tonsil
D. A lymph node
E. Peyer’s patches
C. A tonsil

16. In the image, a layer of the epidermis from thick skin (like on the palms or soles) is marked with a star. This layer mostly contains nucleus-free transitional stages between keratinocytes and fully formed horn cells (corneocytes).
Which layer is it?
A. Stratum basale
B. Stratum corneum
C. Stratum granulosum
D. Stratum lucidum
E. Stratum spinosum
D. Stratum lucidum


17. The image shows a macroscopic specimen of the shoulder region.
The structure marked with arrows in the image is:
A. Not palpable in a living person
B. A part of the clavicle (collarbone)
C. A part of the scapula (shoulder blade)
D. A part of the humerus (upper arm bone)
E. The origin of the long head of the biceps brachii muscle
C. A part of the scapula (shoulder blade)


18. The image shows a macroscopic specimen of the elbow, in which a nerve marked by an arrow has been exposed.
What is the most likely function of the muscles innervated by the nerve marked with the arrow?
A. Internal rotation of the shoulder joint
B. Supination in the radioulnar joints
C. Ulnar abduction at the proximal wrist joint
D. Flexion at the proximal wrist joint
E. Extension in the metacarpophalangeal joints of digits 4 and 5
D. Flexion at the proximal wrist joint

19. The dorsal scapular nerve (N. dorsalis scapulae) is a motor nerve of the brachial plexus.
Which muscle is typically innervated by the dorsal scapular nerve?
A. Levator scapulae muscle
B. Longissimus capitis muscle
C. Splenius capitis muscle
D. Splenius cervicis muscle
E. Trapezius muscle
A. Levator scapulae muscle
20. The two axillary spaces (quadrangular and triangular spaces) are important neurovascular pathways in the shoulder region.
Which structure does not pass through either the medial (triangular) or lateral (quadrangular) axillary space?
A. Anterior circumflex humeral artery (A. circumflexa humeri anterior)
B. Posterior circumflex humeral artery (A. circumflexa humeri posterior)
C. Circumflex scapular artery (A. circumflexa scapulae)
D. Circumflex scapular vein (V. circumflexa scapulae)
E. Axillary nerve (N. axillaris)
A. Anterior circumflex humeral artery (A. circumflexa humeri anterior)

21. A 30-year-old cyclist falls over the handlebars of his mountain bike and braces himself with his hands. The next day, he experiences severe pain and swelling in the left wrist, prompting a visit to a trauma surgery clinic. After examination, a scaphoid fracture is suspected.
In which area of the hand is tenderness most likely to be triggered as a sign of a scaphoid fracture?
A. Ulnar carpal eminence (Eminentia carpi ulnaris)
B. Radial fossa (Anatomical snuffbox / Foveola radialis)
C. Hypothenar region
D. Interosseous space between the third metacarpal bones (Spatium interosseum metacarpi III)
E. Interosseous space between the fourth metacarpal bones (Spatium interosseum metacarpi IV)
B. Radial fossa (Anatomical snuffbox / Foveola radialis)

22. A patient is unable to extend their hand dorsally (wrist drop). A radial nerve (N. radialis) lesion is suspected. Clinical examination also reveals weakness of the brachioradialis muscle.
At which of the following sites is damage to this nerve most likely in this patient?
A. Lateral bicipital groove (Sulcus bicipitalis lateralis)
B. Medial bicipital groove (Sulcus bicipitalis medialis)
C. Radial groove of the humerus (Sulcus nervi radialis)
D. Cubital fossa (Fossa cubitalis)
E. Radiocarpal transition zone
C. Radial groove of the humerus (Sulcus nervi radialis)

23. A 35-year-old front-seat passenger is involved in a car accident and suffers, among other injuries, a dislocation of the right hip joint with tearing of the ligamentous structures.
Hip dislocations are relatively rare because the hip joint is generally well protected by strong bones and ligaments.
Which of the following structures contributes the least to the stabilization of the hip joint?
A. Ligament of the head of the femur (Lig. capitis femoris)
B. Iliofemoral ligament (Lig. iliofemorale)
C. Ischiofemoral ligament (Lig. ischiofemorale)
D. Pubofemoral ligament (Lig. pubofemorale)
E. Zona orbicularis
A. Ligament of the head of the femur (Lig. capitis femoris)

24. During clinical examination, it is observed that when the patient stands on her right leg, her pelvis tilts downward to the left side (Trendelenburg sign).
Weakness of which of the following muscles is most likely responsible for this finding?
A. Right gluteus medius muscle (M. gluteus medius)
B. Right iliopsoas muscle (M. iliopsoas)
C. Right internal obturator muscle (M. obturatorius internus)
D. Right piriformis muscle (M. piriformis)
E. Right quadriceps femoris muscle (M. quadriceps femoris)
A. Right gluteus medius muscle (M. gluteus medius)
25. Which of the following nerve structures is most likely to be damaged?
A. Posterior root of the right spinal nerve S4
B. Right ilioinguinal nerve
C. Right obturator nerve
D. Right saphenous nerve
E. Right tibial nerve
C. Right obturator nerve

26. After surgery for an open lower leg fracture, a 43-year-old female patient develops severe pain in that area during the night. The cause is a compartment syndrome—a dangerous increase in pressure within the tissue—affecting the deep flexor compartment of the lower leg.
Which of the following muscles is most likely to be damaged?
A. Plantaris muscle
B. Fibularis longus muscle
C. Gastrocnemius muscle
D. Soleus muscle
E. Tibialis posterior muscle
E. Tibialis posterior muscle

27. A marathon runner is diagnosed with a march fracture (a stress fracture) of the 2nd metatarsal head due to prolonged strain from her sport. This type of fatigue fracture develops gradually, often without a clear cause, as the ligament and muscle support structures weaken. She experiences pain during foot rollover (walking motion).
Which of the following ligaments plays a key role in maintaining the longitudinal arch of the foot and therefore helps prevent overload injuries of the foot arch?
A. Bifurcate ligament
B. Long plantar ligament
C. Interosseous talocalcaneal ligament
D. Medial talocalcaneal ligament
E. Anterior talofibular ligament
B. Long plantar ligament

28. In the lower leg and foot region, certain muscles cross over each other at specific points known as the Chiasma crurale (crural chiasm) and Chiasma plantare (plantar chiasm).
Which of the following muscle pairs cross over each other at the Chiasma plantare?
A. Adductor hallucis muscle and quadratus plantae muscle
B. Flexor digitorum brevis muscle and adductor hallucis muscle
C. Flexor digitorum longus muscle and flexor hallucis longus muscle
D. Tibialis anterior muscle and quadratus plantae muscle
E. Tibialis posterior muscle and flexor digitorum longus muscle
C. Flexor digitorum longus muscle and flexor hallucis longus muscle

29. During surgical procedures on the sole of the foot, it's important to be aware of the course of the lateral plantar nerve (N. plantaris lateralis).
On which structure does this nerve primarily run—when viewed from the sole—before it branches into its superficial (R. superficialis) and deep (R. profundus) parts?
A. Plantar aponeurosis
B. Abductor hallucis muscle
C. Abductor digiti minimi muscle
D. Flexor digitorum brevis muscle
E. Quadratus plantae muscle
E. Quadratus plantae muscle

30. Back pain is a common reason for seeking medical care. One possible cause of such pain involves the fascia (connective tissue) of the back muscles.
Which of the following structures is directly connected to the layer of the thoracolumbar fascia located between the quadratus lumborum muscle and the erector spinae muscle?
A. Posterior longitudinal ligament
B. Nuchal ligament
C. Costal processes (transverse processes) of the lumbar vertebrae
D. Spinous processes of the thoracic vertebrae
E. Back surface of the sacrum
C. Costal processes (transverse processes) of the lumbar vertebrae

31. An inguinal hernia is the most common type of hernia and primarily affects men. In inguinal hernias, doctors distinguish between an inner hernia opening (toward the abdominal cavity) and an outer hernia opening (toward the skin and subcutaneous tissue).
Where is the inner hernia opening located in the case of an indirect inguinal hernia (hernia inguinalis indirecta)?
A. Medial inguinal fossa
B. Lateral inguinal fossa
C. Supravesical fossa
D. Adductor hiatus
E. Saphenous hiatus
B. Lateral inguinal fossa

32. In the fetal circulation, there are special shortcut connections (called shunts) between blood vessels or heart chambers that help bypass certain organs like the lungs before birth. These shunts normally close after the baby is born.
What does the foramen ovale connect in the fetal heart?
A. Umbilical artery and internal iliac artery
B. Umbilical artery and umbilical vein
C. Aorta and pulmonary trunk
D. Right atrium and left atrium
E. Right ventricle and left ventricle
D. Right atrium and left atrium


33. The image shows a low‑magnification overview of the lung stained with Resorcin‑Fuchsin (highlighting elastic fibres). The regions of tissue marked by a star each have which of the following features?
A. Ciliated epithelial cells (ciliated epithelium)
B. Organ‑specific macrophages
C. Striated skeletal muscle
D. Fenestrated endothelium
E. Ito cells (hepatic stellate‑type cells)
B. Organ‑specific macrophages

34. On a posterior-anterior chest X-ray, a lobar pneumonia of the right middle lobe is visible. It is sharply bordered on the upper side by the horizontal fissure of the lung.
Which of the following best describes the course of the horizontal fissure?
A. Parallel to the 2nd rib
B. Parallel to the 4th rib
C. Parallel to the 6th rib
D. Parallel to the costal arch (arcus costalis)
E. From the 3rd intercostal space dorsally to the 5th intercostal space ventrally
B. Parallel to the 4th rib

35. In tissue samples, a bronchus can be distinguished from a bronchiole based on histological features.
Which of the following structures or cell types is found in a bronchus but not in a bronchiole, making it useful for distinguishing between the two?
A. Elastic fibers
B. Fibroblasts
C. Ciliated epithelium
D. Smooth muscle cells
E. Hyaline cartilage
E. Hyaline cartilage

36. Coronary artery disease (CAD) is one of the most common causes of death in Western countries. It results from atherosclerosis, which narrows the coronary arteries. To prevent heart attacks, various clinical and surgical interventions are used. These rely on a solid understanding of the coronary arteries, which are considered functional end arteries—meaning if they are blocked, there's little to no alternative blood flow.
In a heart with a normal coronary supply pattern, which branch of the left coronary artery (A. coronaria sinistra) is most commonly present?
A. Circumflex branch (Ramus circumflexus)
B. Posterior interventricular branch (Ramus interventricularis posterior)
C. Right marginal branch (Ramus marginalis dexter)
D. Atrioventricular nodal branch (Ramus nodi atrioventricularis)
E. Sinoatrial nodal branch (Ramus nodi sinuatrialis)
A. Circumflex branch (Ramus circumflexus)
37. During a transesophageal echocardiography (TEE), an ultrasound probe is inserted into the esophagus to closely examine the heart. Since the esophagus lies directly behind the heart, certain chambers are better visualized than others.
Which of the following heart chambers is in direct contact with the esophagus and can therefore be best seen using this technique?
A. Right atrium (Atrium dextrum)
B. Left atrium (Atrium sinistrum)
C. Right auricle (Auricula dextra)
D. Right ventricle (Ventriculus dexter)
E. Left ventricle (Ventriculus sinister)
B. Left atrium (Atrium sinistrum)

38. A patient is experiencing pain caused by inflammation of the mediastinal part of the pleura (the inner lining around the lungs near the center of the chest).
Which of the following nerves carries the pain-conducting nerve fibers responsible for this sensation?
A. Phrenic nerve (N. phrenicus)
B. Long thoracic nerve (N. thoracicus longus)
C. Thoracodorsal nerve (N. thoracodorsalis)
D. Cervical cardiac nerves (Nn. cardiaci cervicales)
E. Thoracic cardiac nerves (Nn. cardiaci thoracici)
A. Phrenic nerve (N. phrenicus)

39. Anatomically, the mediastinum is divided into the upper mediastinum and the lower mediastinum. The lower part is further divided into anterior, middle, and posterior mediastinum. A patient with chronic upper back pain is found to have a paravertebral tumor, and surgical exploration of the posterior mediastinum is planned to remove it if possible.
Which of the following structures is most at risk during such a surgical exploration of the posterior mediastinum?
A. Ascending aorta (Aorta ascendens)
B. Aortic arch (Arcus aortae)
C. Thoracic duct (Ductus thoracicus)
D. Brachiocephalic trunk (Truncus brachiocephalicus)
E. Superior vena cava (V. cava superior)
C. Thoracic duct (Ductus thoracicus)

40. The embryonic genital ducts play a key role in forming the reproductive organs and parts of the urinary system. If their development is disrupted, it can lead to malformations.
Which of the following structures develops from the Wolffian ducts (also called mesonephric ducts)?
A. Ductus deferens (vas deferens)
B. Uterine tube (Tuba uterina)
C. Seminiferous tubules (Tubuli seminiferi)
D. Female urethra (Urethra feminina)
E. Male urethra (Urethra masculina)
A. Ductus deferens (vas deferens)
41. In the urinary tract, there are natural narrowing points where kidney stones can most easily get stuck.
Where is one of these typical narrowing points most likely located?
A. At the renal papillae (Nierenpapillen)
B. In the renal sinus (Sinus renalis)
C. At the two upper corners of the bladder trigone (Trigonum vesicae)
D. In the prostatic part of the urethra (Pars prostatica)
E. In the proximal part of the spongy urethra (Pars spongiosa)
C. At the two upper corners of the bladder trigone (Trigonum vesicae)

42. Scar tissue from reduced blood flow can lead to significant narrowing of the ureter (the tube that carries urine from the kidney to the bladder).
Which of the following arteries is least involved in supplying blood to the ureter?
A. Internal pudendal artery (A. pudenda interna)
B. Renal artery (A. renalis)
C. Testicular or ovarian artery (A. testicularis / A. ovarica)
D. Inferior vesical artery (A. vesicalis inferior)
E. Superior vesical artery (A. vesicalis superior)
A. Internal pudendal artery (A. pudenda interna)

43. Urinary incontinence—the involuntary leakage of urine—is a common issue in older adults. In men, maintaining control over urination depends on the proper functioning of specific muscles.
Which muscle plays the most important role in closing the urethra in men?
A. Bulbospongiosus muscle (M. bulbospongiosus)
B. Ischiocavernosus muscle (M. ischiocavernosus)
C. Internal obturator muscle (M. obturatorius internus)
D. External urethral sphincter muscle (M. sphincter urethrae externus)
E. Superficial transverse perineal muscle (M. transversus perinei superficialis)
D. External urethral sphincter muscle (M. sphincter urethrae externus)

44. The nerve supply of the vulva is very important for sexual sensation and function.
Which of the following nerves is least likely to be involved in innervating the vulva?
A. Lateral femoral cutaneous nerve (N. cutaneus femoris lateralis)
B. Posterior femoral cutaneous nerve (N. cutaneus femoris posterior)
C. Genitofemoral nerve (N. genitofemoralis)
D. Ilioinguinal nerve (N. ilioinguinalis)
E. Pudendal nerve (N. pudendus)
A. Lateral femoral cutaneous nerve (N. cutaneus femoris lateralis)

45. Testicular cancer often affects young men, and cancer cells can spread through the lymphatic system to nearby lymph nodes.
Which group of lymph nodes is the most likely first site where testicular cancer spreads (first metastasis)?
A. Iliac lymph nodes (Nodi lymphoidei iliaci)
B. Deep inguinal lymph nodes (Nodi lymphoidei inguinales profundi)
C. Superficial inguinal lymph nodes (Nodi lymphoidei inguinales superficiales)
D. Lumbar lymph nodes (Nodi lymphoidei lumbales)
E. Sacral lymph nodes (Nodi lymphoidei sacrales)
D. Lumbar lymph nodes (Nodi lymphoidei lumbales)
46. In the epididymis, sperm undergo post-testicular maturation, meaning they continue to develop after leaving the testis. At this stage, they are not yet capable of fertilizing an egg (oocyte).
Approximately how far do sperm have to travel within the duct of the epididymis (Ductus epididymidis) before reaching the vas deferens (Ductus deferens)?
A. 5–6 mm
B. 5–6 cm
C. 50–60 cm
D. 5–6 meters
E. 50–60 meters
D. 5–6 meters


47. This histological image shows a section of renal (kidney) tissue, stained with hematoxylin and eosin (H&E). You can see several tubules and a glomerulus clearly.
Which of the following structures is not visible in this image?
A. Proximal tubule
B. Distal tubule
C. Bowman’s capsule
D. Macula densa
E. Collecting duct (Sammelrohr)
E. Collecting duct (Sammelrohr)


48. This image shows an angiogram, which is an X-ray image taken after a contrast agent has been injected through a catheter into an artery. The visible branching pattern indicates which organs or regions the injected artery supplies.
Which of the following arteries belongs to the vascular territory of the contrast-filled artery shown in this image?
A. Appendicular artery (A. appendicularis)
B. Left colic artery (A. colica sinistra)
C. Dorsal pancreatic artery (A. pancreatica dorsalis)
D. Superior rectal artery (A. rectalis superior)
E. Left renal artery (A. renalis sinistra)
A. Appendicular artery (A. appendicularis)


49. Overproduction of hydrochloric acid (HCl) by gastric glands can contribute to the development of gastritis (inflammation of the stomach lining).
Which of the cells labeled A–E in the image is responsible for producing HCl?
A

50. The short gastric arteries (Aa. gastricae breves) supply blood to the fundus of the stomach, the upper curved part near the esophagus.
From which artery do the short gastric arteries arise?
A. Right gastric artery (A. gastrica dextra)
B. Gastroduodenal artery (A. gastroduodenalis)
C. Common hepatic artery (A. hepatica communis)
D. Proper hepatic artery (A. hepatica propria)
E. Splenic artery (A. splenica)
E. Splenic artery (A. splenica)

51. The rectum is the final section of the large intestine, connecting the sigmoid colon to the anal canal. Its blood supply comes from multiple arteries.
Which of the following arteries is least likely to contribute significantly to the blood supply of the rectum?
A. Internal iliac artery (A. iliaca interna)
B. Inferior mesenteric artery (A. mesenterica inferior)
C. Internal pudendal artery (A. pudenda interna)
D. Inferior rectal artery (A. rectalis inferior)
E. Median sacral artery (A. sacralis mediana)
E. Median sacral artery (A. sacralis mediana)
52. The corpus cavernosum recti (or ani) is a vascular cushion—a type of erectile tissue in the anal canal—that plays a key role in fine continence (helping prevent involuntary stool leakage, especially gas and liquid).
Which of the following muscles lies closest to the lumen (inside) of the corpus cavernosum recti (ani)?
A. Muscle of the anal canal (M. canalis analis)
B. Corrugator ani muscle (M. corrugator ani)
C. Levator ani muscle (M. levator ani)
D. Puborectalis muscle (M. puborectalis)
E. External anal sphincter (M. sphincter ani externus)
A. Muscle of the anal canal (M. canalis analis)

53. In the anal canal, the inner lining changes from rectal mucosa to skin (epidermis) at the very end.
Which part of the anal canal is bordered by the linea pectinata (above) and the linea anocutanea (below)?
A. Anal sinuses (Sinus anales)
B. Anal pecten (Pecten analis)
C. Anal valves (Valvulae anales)
D. Columnar zone (Zona columnalis)
E. Anorectal junction (Junctio anorectalis)
B. Anal pecten (Pecten analis)

54. If there's a blockage in the portal vein, blood backs up in the veins that normally drain directly into the portal vein. This can be seen on imaging studies like CT or MRI.
Which of the following veins is most likely to show signs of this backup (congestion) first?
A. Short gastric veins (Vv. gastricae breves)
B. Right gastro-omental vein (V. gastroomentalis dextra)
C. Hepatic veins (Vv. hepaticae)
D. Inferior mesenteric vein (V. mesenterica inferior)
E. Splenic vein (V. splenica)
E. Splenic vein (V. splenica)

55. The spleen is primarily supplied by the sympathetic nervous system, which controls functions like vasoconstriction (narrowing of blood vessels).
In which nerve plexus are the preganglionic sympathetic fibers for the spleen typically synapsed (switched to postganglionic fibers)?
A. Celiac plexus (Plexus coeliacus)
B. Inferior mesenteric plexus (Plexus mesentericus inferior)
C. Superior mesenteric plexus (Plexus mesentericus superior)
D. Renal plexus (Plexus renalis)
E. Testicular/Ovarian plexus (Plexus testicularis/ovaricus)
A. Celiac plexus (Plexus coeliacus)

56. Bacterial infections in the upper lip region can sometimes spread through venous connections and cause dangerous complications, such as meningitis (inflammation of the brain membranes).
Which of the following venous channels is least likely to be involved in the spread of such an infection?
A. Pterygoid plexus (Plexus pterygoideus)
B. Cavernous sinus (Sinus cavernosus)
C. Sigmoid sinus (Sinus sigmoideus)
D. Angular vein (V. angularis)
E. Basal vein (V. basalis)
E. Basal vein (V. basalis)

57. In a traumatic brain injury (TBI), the oculomotor nerve (cranial nerve III) can be affected.
Where does the oculomotor nerve travel?
A. Between the frontal bone (Os frontale) and the ethmoid bone (Os ethmoidale)
B. Through the lesser wing (Ala minor) of the sphenoid bone (Os sphenoidale)
C. Between the medial and lateral plates (Lamina medialis and Lamina lateralis) of the pterygoid process (Processus pterygoideus)
D. Between the greater and lesser wings (Ala major and Ala minor) of the sphenoid bone (Os sphenoidale)
E. Through the greater wing (Ala major) of the sphenoid bone (Os sphenoidale)
D. Between the greater and lesser wings (Ala major and Ala minor) of the sphenoid bone (Os sphenoidale)

58. During swallowing, the connection between the oropharynx (throat) and the nasopharynx (upper part of the throat behind the nose) is closed off. If this closure is not working properly, food or liquid can go up into the nasal cavity, especially when drinking.
Which of the following muscles is most important for closing this passage?
A. Middle pharyngeal constrictor muscle (M. constrictor pharyngis medius)
B. Digastric muscle (M. digastricus)
C. Hyoglossus muscle (M. hyoglossus)
D. Mylohyoid muscle (M. mylohyoideus)
E. Tensor veli palatini muscle (M. tensor veli palatini)
E. Tensor veli palatini muscle (M. tensor veli palatini)

59. A 60-year-old female patient is no longer able to completely close the eyelid of her right eye. A peripheral nerve disorder on the right side is suspected.
Where is this disorder most likely located?
A. Inferior orbital fissure (Fissura orbitalis inferior)
B. Superior orbital fissure (Fissura orbitalis superior)
C. Oval foramen (Foramen ovale)
D. Round foramen (Foramen rotundum)
E. Internal acoustic meatus (Meatus acusticus internus)
E. Internal acoustic meatus (Meatus acusticus internus)

60. Adequate saliva production is essential for processing food in the mouth.
Through which nerve fibers does the preganglionic parasympathetic innervation of the parotid gland (Gl. parotidea) mainly travel?
A. Chorda tympani
B. Auriculotemporal nerve (N. auriculotemporalis)
C. Buccal nerve (N. buccalis)
D. Lesser petrosal nerve (N. petrosus minor)
E. Internal carotid plexus (Plexus caroticus internus)
D. Lesser petrosal nerve (N. petrosus minor)

61. The blood supply to the nose and the paranasal sinuses comes from branches of both the external carotid artery (A. carotis externa) and the internal carotid artery (A. carotis interna).
Which of the following arteries originates from the internal carotid artery?
A. Posterior ethmoidal artery (A. ethmoidalis posterior)
B. Superior labial artery (A. labialis superior)
C. Posterior lateral nasal artery (A. nasalis posterior lateralis)
D. Descending palatine artery (A. palatina descendens)
E. Sphenopalatine artery (A. sphenopalatina)
A. Posterior ethmoidal artery (A. ethmoidalis posterior)

62. The mesolimbic system is known as the brain’s reward system and plays a key role in addiction. The nucleus accumbens (Ncl. accumbens) has a central function in this system.
Where in the brain is the nucleus accumbens located?
A. In the reticular formation of the metencephalon
B. In the metathalamus
C. In the basal forebrain (basales Vorderhirn)
D. At the edge of the insula
E. In the basal temporal lobe (basaler Schläfenlappen)
C. In the basal forebrain (basales Vorderhirn)


63. Spinal cord injuries can lead to various neurological deficits due to damage to ascending and descending nerve tracts.
Which of the following tracts is most likely located in the area of white matter marked by the asterisk (*) in the image?
A. Fasciculus cuneatus
B. Fasciculus gracilis
C. Lateral corticospinal tract (Tractus corticospinalis lateralis)
D. Posterior spinocerebellar tract (Tractus spinocerebellaris posterior)
E. Lateral spinothalamic tract (Tractus spinothalamicus lateralis)
C. Lateral corticospinal tract (Tractus corticospinalis lateralis)


64. Which number marks the metencephalon?
(The image shows a brain cut down the middle, viewed from the inside.)
A. 1
B. 2
C. 3
D. 4
E. 5
D. 4


65. Which cranial nerves are marked with arrows?
(The image shows the brainstem viewed from a lower-back angle — "oblique caudal view.")
A. N. trigeminus and N. facialis
B. N. facialis and N. vestibulocochlearis
C. N. vestibulocochlearis and N. glossopharyngeus
D. N. glossopharyngeus and N. vagus
E. N. vagus and N. accessorius
B. N. facialis and N. vestibulocochlearis


66. Which letter marks the pulvinar of the thalamus in the brain section shown?
A. A
B. B
C. C
D. D
E. E
D. D

67. In which of the following nerves do the fibers of the efferent limb of the corneal reflex run?
A. N. facialis
B. N. maxillaris
C. N. ophthalmicus
D. N. petrosus major
E. N. trochlearis
A. N. facialis

68. Which structure is part of the central auditory pathway?
A. Colliculus inferior
B. Corpus geniculatum laterale
C. Nucleus cuneatus
D. Nucleus olivaris inferior
E. Parietal operculum
A. Colliculus inferior
69. The Purkinje cells of the cerebellum are multipolar nerve cells that play an important role in motor control.
The Purkinje cells in the paravermal zone of the cerebellum project primarily to which structure(s)?
A. Formatio reticularis
B. Nucleus dentatus
C. Nucleus emboliformis and Nucleus globosus
D. Nucleus fastigii
E. Vestibular nuclei
C. Nucleus emboliformis and Nucleus globosus

70. A patient has a visual field defect affecting the lower right quadrants of the visual fields in both eyes.
Which of the following structures is most likely damaged?
A. Outer layers of the right lateral geniculate body (Corpus geniculatum laterale)
B. Inner nerve fibers of the right optic tract (Tractus opticus)
C. Left brachium of the inferior colliculus
D. Left cerebral cortex above the calcarine sulcus
E. Non-crossing fibers of the left optic nerve (N. opticus)
D. Left cerebral cortex above the calcarine sulcus

71. In spontaneous intracerebral hemorrhages due to arterial hypertension, the anterolateral central arteries (also called lenticulostriate arteries) are often involved.
From which of the following vessels do these arteries most commonly originate?
A. Anterior cerebral artery (A. cerebri anterior)
B. Anterior communicating artery (A. communicans anterior)
C. Middle cerebral artery (A. cerebri media)
D. Posterior cerebral artery (A. cerebri posterior)
E. Posterior communicating artery (A. communicans posterior)
C. Middle cerebral artery (A. cerebri media)
72. The eye develops from various embryonic origin structures.
Which of the following structures develops directly as part of the diencephalon?
A. The lens (Augenlinse)
B. The choroid (Choroidea)
C. The vitreous body (Glaskörper)
D. The retina
E. The sclera
D. The retina

73. Increased intraocular pressure (glaucoma) can occur especially in older patients, sometimes due to increased production of aqueous humor.
Where is aqueous humor produced?
A. Cornea
B. Ciliary body (Corpus ciliare)
C. Vitreous body (Corpus vitreum)
D. Iris
E. Optic disc (Papilla nervi optici)
B. Ciliary body (Corpus ciliare)
74. The tear film is made up of three main layers, and its composition is disturbed in "dry eye" disease, which affects millions of people worldwide.
Which structure(s) are primarily responsible for producing the mucous component of the tear film?
A. Conjunctiva
B. Ciliary glands (Gll. ciliares, Moll)
C. Sebaceous glands (Gll. sebaceae, Zeis)
D. Tarsal glands (Gll. tarsales, Meibom)
E. Lacrimal sac (Saccus lacrimalis)
A. Conjunctiva

75. In a middle ear infection (otitis media), rupture of the tympanic membrane (eardrum) with drainage of pus can relieve pain.
Which of the following nerves most likely provides sensory innervation to the inner (middle ear-facing) side of the tympanic membrane?
A. Great auricular nerve (N. auricularis magnus)
B. Auriculotemporal nerve (N. auriculotemporalis)
C. Facial nerve (N. facialis)
D. Glossopharyngeal nerve (N. glossopharyngeus)
E. Vagus nerve (N. vagus)
D. Glossopharyngeal nerve (N. glossopharyngeus)
76. Dizziness can be caused, among other things, by circulation problems in the inner ear.
Which artery most directly supplies the hearing and balance organs?
A. Artery caroticotympanica
B. Artery labyrinthi
C. Artery stylomastoidea
D. Posterior tympanic artery (A. tympanica posterior)
E. Superior tympanic artery (A. tympanica superior)
B. Artery labyrinthi